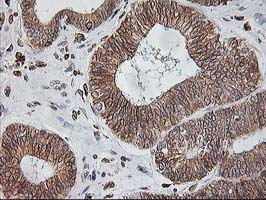

The signal sequence receptor (SSR) is a glycosylated endoplasmic reticulum (ER) membrane receptor associated with protein translocation across the ER membrane. The SSR consists of 2 subunits, a 34-kD glycoprotein encoded by this gene and a 22-kD glycoprotein. This gene generates several mRNA species as a result of complex alternative polyadenylation. This gene is unusual in that it utilizes arrays of polyA signal sequences that are mostly non-canonical. [provided by RefSeq]. COMPLETENESS: complete on the 3' end.
推荐稀释比 WB:1/500-1/1000;IHC:1/50-1/100
Immunohistochemistry analysis of paraffin-embedded Adenocarcinoma of Human endometrium tissue using SSR1 antibody.High-pressure and temperature Sodium Citrate pH 6.0 was used for antigen retrieval.
Store at 4°C short term. Aliquot and store at -52°C long term. Avoid freeze/thaw cycles.





